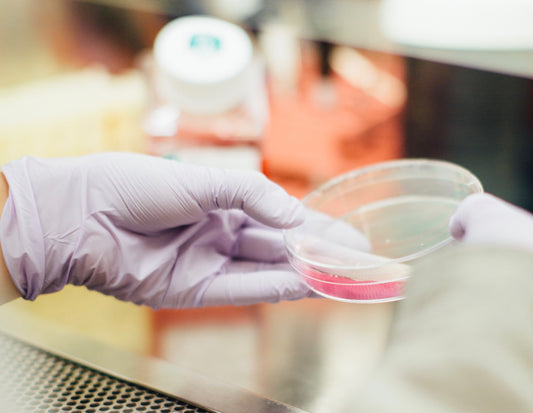
Formulation vs Ingredients

Skincare Bible
Formulation vs Ingredients
Formulation vs Ingredients How many of you consider how your skincare products are actually formulated? Many people tend to focus on the ingredients in a product, rather than the formulation...which...
Formulation vs Ingredients
Formulation vs Ingredients How many of you consider how your skincare products are actually formulated? Many people tend to focus on the ingredients in a product, rather than the formulation...which...

All about Shea Butter
Shea Butter has many benefits for your skin, with its protecting, moisturising and skin regenerating qualities it works wonders. Use Shea Butter as a... 1. Natural Moisturiser Shea Butter is...
All about Shea Butter
Shea Butter has many benefits for your skin, with its protecting, moisturising and skin regenerating qualities it works wonders. Use Shea Butter as a... 1. Natural Moisturiser Shea Butter is...

6 Teas for Healthier & Glowing Skin
Drinking tea can have so many benefits for your skin. See 6 best teas for Healthier & Glowing Skin.
6 Teas for Healthier & Glowing Skin
Drinking tea can have so many benefits for your skin. See 6 best teas for Healthier & Glowing Skin.

Summer Skincare Routine
Everyone wants glowing skin! We have the perfect morning and night time skincare routine so you can glow all summer! Morning Step 1 Cleanse Cleansing is essential to removing dirt...
Summer Skincare Routine
Everyone wants glowing skin! We have the perfect morning and night time skincare routine so you can glow all summer! Morning Step 1 Cleanse Cleansing is essential to removing dirt...

Hyperpigmentation - best skincare for dark marks
Having dark spots, uneven skin tone or inflammatory skin is annoying. Whether you have fair or dark skin, or something in between, here’s our guide to the best solutions for your hyperpigmentation. Hyperpigmentation...
Hyperpigmentation - best skincare for dark marks
Having dark spots, uneven skin tone or inflammatory skin is annoying. Whether you have fair or dark skin, or something in between, here’s our guide to the best solutions for your hyperpigmentation. Hyperpigmentation...
Is Sunscreen in Makeup enough?
We hear this question from our readers all time... "If my foundation has SPF 50, do I need to wear sunscreen under it?" Well keep reading to find out the...
Is Sunscreen in Makeup enough?
We hear this question from our readers all time... "If my foundation has SPF 50, do I need to wear sunscreen under it?" Well keep reading to find out the...